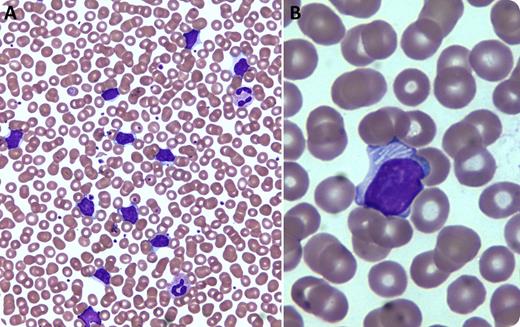
An 84-year-old man with Rai stage 1 chronic lymphocytic leukemia (CLL) and an immunoglobulin (Ig)M λ paraprotein in serum (0.16 g/dL) presented for routine follow-up. The monoclonal B-cell immunophenotype was previously reported as λ light chain-restricted CD19+CD20 (low density)+CD5+CD10−CD23+CD22−CD21+CD43+FMC7−CD11c− surface IgM+; prognostic factors included CD38− and only 13q− by in situ hybridization, both associated with a favorable prognosis. Total white cell count was 48 700/μL (89% lymphocytes) with no anemia or thrombocytopenia. Wright-Giemsa-stained peripheral blood smear examination revealed numerous moderate-sized abnormal lymphocytes with irregular nuclei and moderate cytoplasm, but only rare visible nucleoli, atypical for CLL (panel A; ×50 magnification). About 20% of the abnormal lymphocytes possessed pale-to-white, tubular “filamentous-like” cytoplasmic inclusions (panel B; ×100 magnification). / Cytoplasmic inclusions in the abnormal lymphocytes of CLL are rare, although some observations of similar filamentous-like structures have been reported. Previous studies have indicated that these inclusions represent rough endoplasmic reticula that have become visible as a result of dilation and filling with immunoglobulin deposits. Although only a handful of cases have been reported and atypical morphology such as seen in this patient correlates with less favorable prognosis, the inclusions per se do not appear to have clinical significance.

An 84-year-old man with Rai stage 1 chronic lymphocytic leukemia (CLL) and an immunoglobulin (Ig)M λ paraprotein in serum (0.16 g/dL) presented for routine follow-up. The monoclonal B-cell immunophenotype was previously reported as λ light chain-restricted CD19+CD20 (low density)+CD5+CD10−CD23+CD22−CD21+CD43+FMC7−CD11c− surface IgM+; prognostic factors included CD38− and only 13q− by in situ hybridization, both associated with a favorable prognosis. Total white cell count was 48 700/μL (89% lymphocytes) with no anemia or thrombocytopenia. Wright-Giemsa-stained peripheral blood smear examination revealed numerous moderate-sized abnormal lymphocytes with irregular nuclei and moderate cytoplasm, but only rare visible nucleoli, atypical for CLL (panel A; ×50 magnification). About 20% of the abnormal lymphocytes possessed pale-to-white, tubular “filamentous-like” cytoplasmic inclusions (panel B; ×100 magnification).
Cytoplasmic inclusions in the abnormal lymphocytes of CLL are rare, although some observations of similar filamentous-like structures have been reported. Previous studies have indicated that these inclusions represent rough endoplasmic reticula that have become visible as a result of dilation and filling with immunoglobulin deposits. Although only a handful of cases have been reported and atypical morphology such as seen in this patient correlates with less favorable prognosis, the inclusions per se do not appear to have clinical significance.
An 84-year-old man with Rai stage 1 chronic lymphocytic leukemia (CLL) and an immunoglobulin (Ig)M λ paraprotein in serum (0.16 g/dL) presented for routine follow-up. The monoclonal B-cell immunophenotype was previously reported as λ light chain-restricted CD19+CD20 (low density)+CD5+CD10−CD23+CD22−CD21+CD43+FMC7−CD11c− surface IgM+; prognostic factors included CD38− and only 13q− by in situ hybridization, both associated with a favorable prognosis. Total white cell count was 48 700/μL (89% lymphocytes) with no anemia or thrombocytopenia. Wright-Giemsa-stained peripheral blood smear examination revealed numerous moderate-sized abnormal lymphocytes with irregular nuclei and moderate cytoplasm, but only rare visible nucleoli, atypical for CLL (panel A; ×50 magnification). About 20% of the abnormal lymphocytes possessed pale-to-white, tubular “filamentous-like” cytoplasmic inclusions (panel B; ×100 magnification).
Cytoplasmic inclusions in the abnormal lymphocytes of CLL are rare, although some observations of similar filamentous-like structures have been reported. Previous studies have indicated that these inclusions represent rough endoplasmic reticula that have become visible as a result of dilation and filling with immunoglobulin deposits. Although only a handful of cases have been reported and atypical morphology such as seen in this patient correlates with less favorable prognosis, the inclusions per se do not appear to have clinical significance.
For additional images, visit the ASH IMAGE BANK, a reference and teaching tool that is continually updated with new atlas and case study images. For more information visit http://imagebank.hematology.org.

This feature is available to Subscribers Only
Sign In or Create an Account Close Modal